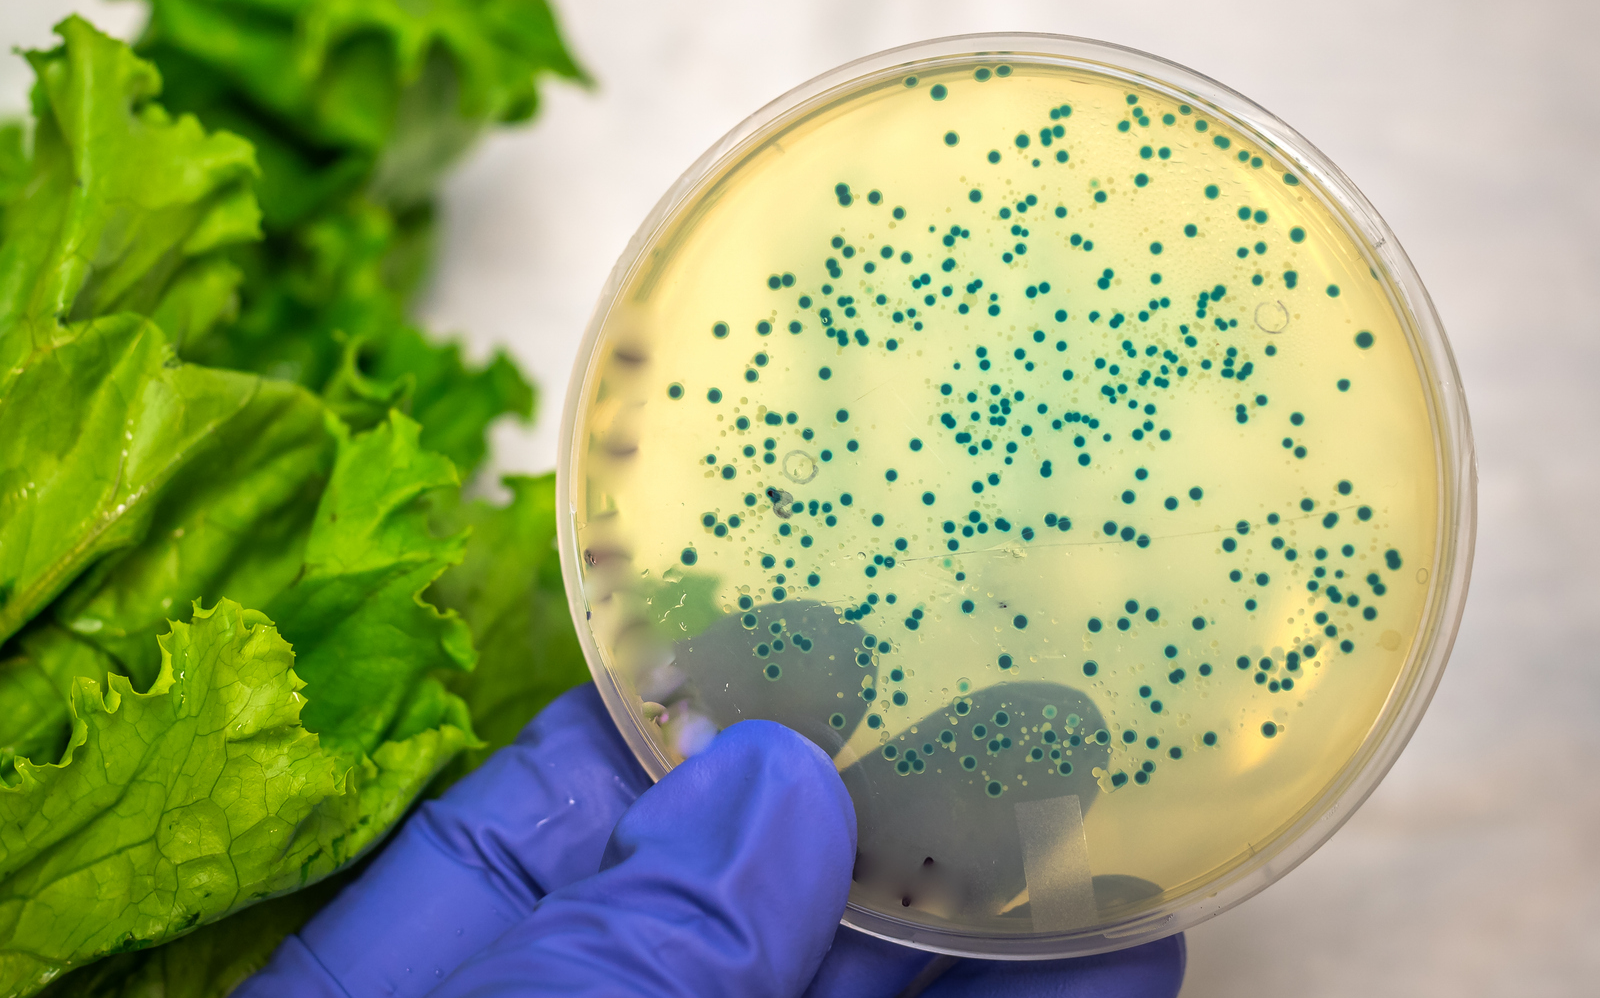
les symptômes de la listériose

Fièvre et frissons, douleurs musculaires, nausées et diarrhées… Infection d’origine alimentaire, la listériose provoque des symptômes peu spécifiques. Mais même si elle reste rare, elle peut entraîner de graves complications chez les personnes fragiles. En présence de certains signes, il est donc indispensable de consulter rapidement.
Alors comment reconnaître les symptômes de la listériose ? Comment attrape-t-on cette maladie ? Et comment l’éviter ?
Qu’est-ce que la listériose ?
Maladie à déclaration obligatoire, la listériose est une infection d’origine alimentaire. Elle est due à l'ingestion d’un aliment contaminé par la bactérie Listeria monocytogenes. Si elle reste rare, elle peut être particulièrement grave chez certaines personnes (les femmes enceintes, notamment).
Une infection due à la bactérie Listeria monocytogenes
La listériose est une maladie infectieuse, due à l’ingestion de la bactérie Listeria monocytogenes. Très répandue dans l’environnement (les sols, l’eau des rivières et des lacs), on retrouve aussi cette bactérie de petite taille dans les intestins des animaux domestiques (donc dans leurs excréments) et dans les végétaux en décomposition. La bactérie Listeria monocytogenes est particulièrement résistante : elle peut se multiplier à basse ou à très basse température (jusqu’à 4 °C), et vivre pendant des années sur des surfaces ou des objets souillés. Elle se développe donc facilement dans les réfrigérateurs et les congélateurs ménagers, ainsi que sur les sites de fabrication des aliments. La nourriture est contaminée par la bactérie, qui est ensuite ingérée par l’homme.
Dans la quasi-totalité des cas, la bactérie est transmise par voie alimentaire, après l’ingestion de produits laitiers ou carnés, crus ou peu cuits : les fromages à pâte molle et au lait cru, le lait cru, les viandes, certaines charcuteries, les poissons fumés, les légumes… La contamination peut aussi avoir lieu lorsque l’on porte ses doigts à la bouche après avoir manipulé un aliment contaminé, ou les ustensiles qui ont permis de le préparer (lorsque l’on utilise le couteau qui a servi à couper une viande crue, par exemple). La bactérie n’altère pas le goût des aliments : il est donc possible de l’ingérer en grandes quantités et de manière fréquente, sans s’en rendre compte. Heureusement, la bactérie reste sensible à la chaleur : elle est détruite après une cuisson de 30 minutes à 60 °C.
Une maladie rare, mais potentiellement grave
La listériose est une maladie rare en France : aujourd’hui, on ne recense environ 600 de listériose aiguë en 2024. Dans la plupart des cas, la listériose ne provoque aucun symptôme, ou les simples symptômes d’une gastro-entérite : des symptômes digestifs, des douleurs musculaires, et parfois de la fièvre et des frissons. Aucun diagnostic n’est posé, et le malade guérit spontanément au bout de quelques jours. Mais la maladie peut avoir de graves conséquences chez certaines personnes fragiles : les femmes enceintes, les nouveaux-nés et les personnes au système immunitaire affaibli (les personnes âgées et les personnes immunodéprimées). Il s’agit en effet de la 2ème cause de mortalité d’origine alimentaire en France.
Chez la femme enceinte, la listériose est une infection qui peut être particulièrement grave. La bactérie peut en effet être transmise au fœtus par le placenta, affecter son développement et entraîner une fausse couche (et son décès, notamment si l’infection survient pendant le premier semestre de grossesse). Si l’infection a lieu entre le 6ème et le 9ème mois de grossesse, la listériose peut être responsable d’un accouchement prématuré. Au moment de l’accouchement, la listériose peut aussi être transmise au nouveau-né et être à l’origine d’une grave infection néonatale. Les enfants contaminés sont suivis jusqu’à l’adolescence, et peuvent présenter des séquelles neurologiques et un retard mental. Pour éviter d’être contaminée, la femme enceinte doit donc éviter de consommer certains types d’aliments pendant sa grossesse, et respecter plusieurs règles d’hygiène. Chez les personnes fragiles, la listériose peut aussi entraîner plusieurs troubles graves, comme une septicémie ou une infection du système nerveux central.
Quels sont les symptômes de la listériose ?
Les symptômes de la listériose se manifestent 2 à 30 jours après la consommation d’un aliment contaminé (en moyenne 10 à 28 jours après, parfois jusqu’à 70 jours après). Si elle reste en général bénigne, l’infection peut parfois être à l’origine de certaines complications.
Des symptômes bénins
Peu spécifiques, les symptômes de la listériose s’apparentent à ceux d’une gastro-entérite, avec :
- de la fièvre et des frissons : plus ou moins élevée, la fièvre peut être accompagnée de maux de tête ;
- des douleurs musculaires (courbatures) ;
- des troubles digestifs : des nausées, des vomissements et des diarrhées.
La nature et l’intensité des symptômes varient selon les individus. La maladie ne provoque pas toujours de signes visibles (chez la femme enceinte, elle peut par exemple être responsable d’une fièvre modérée et isolée, ou évoquer les symptômes d’une grippe). Mais chez les personnes fragiles (âgées ou immunodéprimées), la listériose peut entraîner d’autres signes et certaines complications.
Des complications plus sérieuses
Lorsque les symptômes amènent à consulter et que le diagnostic est confirmé, il s’agit le plus souvent d’une listériose « invasive ». La bactérie s’est propagée à d’autres organes (au-delà du tube digestif) et l’infection se manifeste sous d’autres formes.
Chez les personnes fragiles, l’infection peut par exemple être à l’origine d’une atteinte neurologique (une méningite ou une méningo-encéphalite), et responsable de plusieurs symptômes : de la fièvre et des maux de tête, des nausées et des vomissements, et parfois des troubles du comportement. Des symptômes neurologiques peuvent ensuite persister. Si la bactérie passe dans le sang, on parle de « listériose bactériémique », avec l’apparition de fièvre ou de frissons. Une bactériémie peut aussi engendrer une infection des prothèses portées par certains patients (prothèses articulaires ou vasculaires). Même si cela reste rare, la listériose peut enfin être à l’origine d’une pleurésie ou d’une pneumonie (infection pulmonaire).
Comment réagir en cas de symptômes ?
Toute fièvre inexpliquée chez la femme enceinte doit amener à consulter en urgence, comme l’apparition de certains symptômes chez les personnes âgées ou immunodéprimées, et chez les nourrissons (vomissements, diarrhées ou constipation, maux de tête, fièvre…).
Si le médecin suspecte une listériose, il recherche la présence de la bactérie Listeria monocytogenes dans l’organisme. Pour cela, il a recours à des analyses microbiologiques : il réalise une hémoculture (prise de sang) ou un prélèvement de liquide céphalo-rachidien (ponction lombaire). Chez la femme enceinte, il peut réaliser un prélèvement vaginal ou à un prélèvement de placenta. Il peut aussi analyser le liquide gastrique chez le nouveau-né, ou faire un prélèvement de liquide pleural ou de liquide articulaire. Depuis 1998, la listériose est une maladie à déclaration obligatoire. Dès qu’ils détectent un cas, le médecin et le laboratoire d’analyses médicales doivent informer les autorités sanitaires.
Le traitement d’une listériose sévère passe par l’administration d’antibiotiques, pendant 2 à 3 semaines (le plus souvent, sous hospitalisation). Si la femme enceinte est infectée, une naissance anticipée lui est proposée (lorsque cela est possible) ; le traitement antibiotique est ensuite administré le plus vite possible. Les personnes âgées ou immunodéprimées sont généralement hospitalisées (25 à 30 % des personnes infectées décèdent).
Comment éviter de contracter cette maladie ?
Pour prévenir l’infection par la bactérie Listeria monocytogenes, il faut éviter de consommer certains aliments. Il est également indispensable de respecter plusieurs mesures d’hygiène au moment pour la préparation et la conservation des aliments.
Il est ainsi recommandé aux femmes enceintes, aux personnes immunodéprimées et aux personnes âgées de :
- ne pas consommer d’aliments à risque : certains produits laitiers (lait cru, fromages à pâte molle, au lait cru, à croûte fleurie ou lavée, produits laitiers au lait cru, fromage vendu râpé…), les produits de la mer (coquillages crus comme les huîtres, poissons fumés comme le hareng ou le saumon, tarama, surimi…), les graines germées crues et la charcuterie (jambon cuit ou cru, foie gras, pâté, rillettes, produits en gelée…) ;
- bien préparer les aliments : avant de se lancer dans la préparation d’un repas, il faut bien se laver les mains et nettoyer tous les ustensiles nécessaires. Les aliments crus et cuits ne doivent pas être préparés avec les mêmes ustensiles. Les légumes crus et les herbes aromatiques doivent être bien nettoyés, et il est conseillé de privilégier les aliments emballés (et d’éviter les produits à la coupe). Tous les aliments crus d’origine animale doivent être bien cuits (mijotés plutôt que grillés), et la croûte des fromages retirée. Il faut enfin nettoyer les surfaces en contact avec les aliments crus, et se laver les mains après la préparation du repas ;
- bien conserver les aliments : il faut d'abord bien respecter les dates limites de consommation indiquées sur les emballages des produits, ainsi que les consignes de température de stockage. Les aliments crus doivent être conservés séparément, et tous les produits protégés par du film alimentaire (ou stockés dans une boite hermétique). La température du réfrigérateur doit être maintenue entre 0 °C et 4 °C. Les restes de plats préparés ne doivent pas être conservés plus de 3 jours au réfrigérateur, et l’intérieur de l’appareil souvent nettoyé (à l’eau savonneuse, puis rincé à l’eau légèrement javellisée).
Sources :
https://www.vidal.fr/maladies/estomac-intestins/listeriose.html
https://www.pasteur.fr/fr/centre-medical/fiches-maladies/listeriose